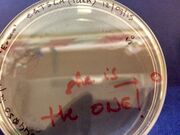

Uploads by Edoardo Gianni
From OpenWetWare
Jump to navigationJump to search
This special page shows all uploaded files.
| Date | Name | Thumbnail | Size | Description |
|---|---|---|---|---|
| 17:13, 21 October 2015 | SPLICEtable.png (file) |  |
18 KB | |
| 21:23, 21 September 2015 | CAFE diagram2.png (file) |  |
32 KB | |
| 21:22, 21 September 2015 | CAFE diagram1.png (file) |  |
48 KB | |
| 21:09, 21 September 2015 | CAFE machine.png (file) |  |
852 KB | |
| 22:50, 20 September 2015 | Splicevsslice.png (file) |  |
1.73 MB | |
| 22:49, 20 September 2015 | Sheistheone.jpeg (file) | |
1.26 MB | |
| 22:49, 20 September 2015 | Lysate illustration.png (file) |  |
156 KB | |
| 11:36, 16 September 2015 | BIG-Biohack logo.png (file) |  |
101 KB | |
| 11:17, 16 September 2015 | Biohack logo-2.png (file) |  |
23 KB |